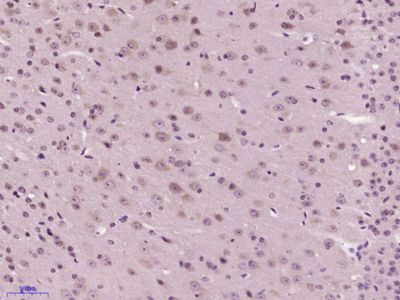
产品细节图片2

相关产品推荐更多 >
万千商家帮你免费找货
0 人在求购买到急需产品
- 详细信息
- 文献和实验
- 技术资料
- 供应商:
上海联迈生物工程有限公司
- 库存:
大量
- 目录编号:
LM-1131R
- 克隆性:
多克隆
- 抗原来源:
Rabbit
- 保质期:
1年
- 抗体英文名:
SNAP25
- 抗体名:
突触相关蛋白25抗体
- 宿主:
Rabbit
- 适应物种:
Human, Mouse, Rat, Chicken, Cow, Rabbit,
- 免疫原:
KLH conjugated synthetic peptide derived from human SNAP-25:166-206/206
- 亚型:
IgG
- 形态:
Lyophilized or Liquid
- 应用范围:
WB=1:500-2000 ELISA=1:500-1000 IHC-P=1:400-800 IHC-F=1:400-800 IF=1:100-500 (石蜡切片需做抗原修复)
- 浓度:
1mg/ml
- 保存条件:
Store at -20 °C
- 规格:
50ul 100ul 200ul
| 英文名称 | SNAP25 |
| 中文名称 | 突触相关蛋白25抗体 |
| 别 名 | SNAP25; SNAP-25; bA416N4.2; Bdr; dJ1068F16.2; FLJ23079; HGNC:11132; MGC105414; MGC139754; Resistance to inhibitors of cholinesterase 4 homolog; RIC 4; RIC4; SEC9; SNAP 25; SNAP; SNAP-25B; SNP 25; SNP25; sp; SUP; Super protein; Synaptosomal associated 25 kDa protein; Synaptosomal associated protein; Synaptosomal Associated Protein 25; Synaptosomal associated protein 25kDa; SNP25_HUMAN . |
![]() |
Specific References (1) | bs-1131R has been referenced in 1 publications. [IF=5.47] Wang, Wei, et al. "SNAP25 Ameliorates Sensory Deficit in Rats with Spinal Cord Transection." Molecular Neurobiology (2014): 1-15. IHC-F ; Rat. PubMed:24519330 |
| 规格价格 | 50ul/780元 购买 100ul/1380元 购买 200ul/2200元 购买 大包装/询价 |
| 说 明 书 | 50ul 100ul 200ul |
| 研究领域 | 细胞生物 神经生物学 信号转导 生长因子和激素 |
| 抗体来源 | Rabbit |
| 克隆类型 | Polyclonal |
| 交叉反应 | Human, Mouse, Rat, Chicken, Cow, Rabbit, |
| 产品应用 | WB=1:500-2000 ELISA=1:500-1000 IHC-P=1:400-800 IHC-F=1:400-800 IF=1:100-500 (石蜡切片需做抗原修复) not yet tested in other applications. optimal dilutions/concentrations should be determined by the end user. |
| 分 子 量 | 23kDa |
| 细胞定位 | 细胞浆 细胞膜 |
| 性 状 | Lyophilized or Liquid |
| 浓 度 | 1mg/ml |
| 免 疫 原 | KLH conjugated synthetic peptide derived from human SNAP-25:166-206/206 |
| 亚 型 | IgG |
| 纯化方法 | affinity purified by Protein A |
| 储 存 液 | 0.01M TBS(pH7.4) with 1% BSA, 0.03% Proclin300 and 50% Glycerol. |
| 保存条件 | Store at -20 °C for one year. Avoid repeated freeze/thaw cycles. The lyophilized antibody is stable at room temperature for at least one month and for greater than a year when kept at -20°C. When reconstituted in sterile pH 7.4 0.01M PBS or diluent of antibody the antibody is stable for at least two weeks at 2-4 °C. |
| PubMed | PubMed |
| 产品介绍 | background: Synaptosomal associated protein 25 kDa (snap-25) is a widely distributed membrane-associated protein in the brain, mainly localized in nerve terminals. Function: t-SNARE involved in the molecular regulation of neurotransmitter release. May play an important role in the synaptic function of specific neuronal systems. Associates with proteins involved in vesicle docking and membrane fusion. Regulates plasma membrane recycling through its interaction with CENPF. Subunit: Part of the SNARE core complex containing SNAP25, VAMP2 and STX1A. This complex binds CPLX1. Interacts with CENPF, TRIM9, RIMS1, SNAPIN, OTOF and HGS. Binds STXBP6. Found in a ternary complex with STX1A and VAMP8. Found in a complex containing SYT1, SV2B and syntaxin-1. Subcellular Location: Cytoplasm, perinuclear region. Cell membrane; Lipid-anchor. Cell junction, synapse, synaptosome. Tissue Specificity: Neurons of the neocortex, hippocampus, piriform cortex, anterior thalamic nuclei, pontine nuclei, and granule cells of the cerebellum. Post-translational modifications: Palmitoylated. Cys-85 appears to be the main site, and palmitoylation is required for membrane association. Similarity: Belongs to the SNAP-25 family. Contains 2 t-SNARE coiled-coil homology domains. SWISS: P60880 Gene ID: 6616 Database links: Entrez Gene: 6616 Human Entrez Gene: 20614 Mouse Entrez Gene: 25012 Rat Entrez Gene: 30712 Zebrafish Omim: 600322 Human SwissProt: P60880 Human SwissProt: P60879 Mouse SwissProt: P60881 Rat Unigene: 167317 Human Unigene: 45953 Mouse Unigene: 107689 Rat Important Note: This product as supplied is intended for research use only, not for use in human, therapeutic or diagnostic applications. |
| 产品图片 | ![]() Paraformaldehyde-fixed, paraffin embedded (Mouse brain); Antigen retrieval by boiling in sodium citrate buffer (pH6.0) for 15min; Block endogenous peroxidase by 3% hydrogen peroxide for 20 minutes; Blocking buffer (normal goat serum) at 37°C for 30min; Antibody incubation with (SNAP25) Polyclonal Antibody, Unconjugated (bs-1131R) at 1:400 overnight at 4°C, followed by operating according to SP Kit(Rabbit) (sp-0023) instructionsand DAB staining. ![]() Tissue/cell: rat brain tissue; 4% Paraformaldehyde-fixed and paraffin-embedded; Antigen retrieval: citrate buffer ( 0.01M, pH 6.0 ), Boiling bathing for 15min; Block endogenous peroxidase by 3% Hydrogen peroxide for 30min; Blocking buffer (normal goat serum,C-0005) at 37℃ for 20 min; Incubation: Anti-SNAP-25 Polyclonal Antibody, Unconjugated(bs-1131R) 1:200, overnight at 4°C, followed by conjugation to the secondary antibody(SP-0023) and DAB(C-0010) staining ![]() Tissue/cell: rat brain tissue;4% Paraformaldehyde-fixed and paraffin-embedded; Antigen retrieval: citrate buffer ( 0.01M, pH 6.0 ), Boiling bathing for 15min; Blocking buffer (normal goat serum,C-0005) at 37℃ for 20 min; Incubation: Anti-SNAP-25 Polyclonal Antibody, Unconjugated(bs-1131R) 1:200, overnight at 4°C; The secondary antibody was Goat Anti-Rabbit IgG, FITC conjugated(bs-0295G-FITC)used at 1:200 dilution for 40 minutes at 37°C. |
风险提示:丁香通仅作为第三方平台,为商家信息发布提供平台空间。用户咨询产品时请注意保护个人信息及财产安全,合理判断,谨慎选购商品,商家和用户对交易行为负责。对于医疗器械类产品,请先查证核实企业经营资质和医疗器械产品注册证情况。
文献和实验的建模方式主要有以下四种,相比来说活体注射 α-突触核蛋白模型的优势更为显著,能够模拟早期、晚期的病理特征,最接近人类真实的发病情况,时间和费用的成本也相对较低。 1.神经毒素模型 例如 6-羟基多巴胺(6-OHDA)和 1-甲基-4-苯基-1,2,3,6-四氢吡啶(MPTP)模型。这类模型的应用较早,而且相关发表文献多,建模快且便宜,优点显而易见。 但是该模型一个很明显的缺点是不能模拟 ASYN 和路易小体病理现象,也就发病早期的现象,这是因为神经毒素直接损伤了神经元,出现运动缺陷太快,不能很好
技术原理与方法|超级色差校正物镜 PLAPON60XOSC 在脑组织四重免疫荧光分析中的应用
种类型的荧光抗体在单个标本中准确展示荧光标记分子的共定位情况。 PLAPON60XOSC 和 UPLSAPO60XO 的性能比较 2. 超级色差校正物镜的应用-脑组织的四重免疫荧光 图 1. 脑组织的四重免疫荧光。 VIAAT 染色(Alexa Fluor405,蓝色);CB1 染色(Alexa Fluor488,绿色);VGluT3 染色(Cy3,红色);DGLα染色(Alexa Fluor647,白色)。 大麻素合成酶 DGLα(白色)和大麻素受体 CB1(绿色)聚集在小鼠
这个微量元素太重要!激活 T 细胞、增强机体免疫,助力抗癌抗感染……Cell 揭开其中奥秘
功能相关抗原 1(LFA-1),后者可通过免疫突触的形成参与 T 细胞的活化,以及白细胞的转运和外渗。 随后,他们发现,LFA-1 在 CD8+ T 细胞中表达最低,在记忆效应 CD8+ T 细胞中表达较高,而在 T 细胞前体细胞中含量最高。进一步的实验证明记忆效应 CD8+ T 细胞选择性依赖 Mg2+进行代谢重编程和激活。LFA-1 的分子构象解析也发现,Mg2+对 LFA-1 的构象改变具有调节作用,这对于由外向内的信号传导和下游的 T 细胞激活至关重要。 图片来源:Cell Mg
技术资料暂无技术资料 索取技术资料